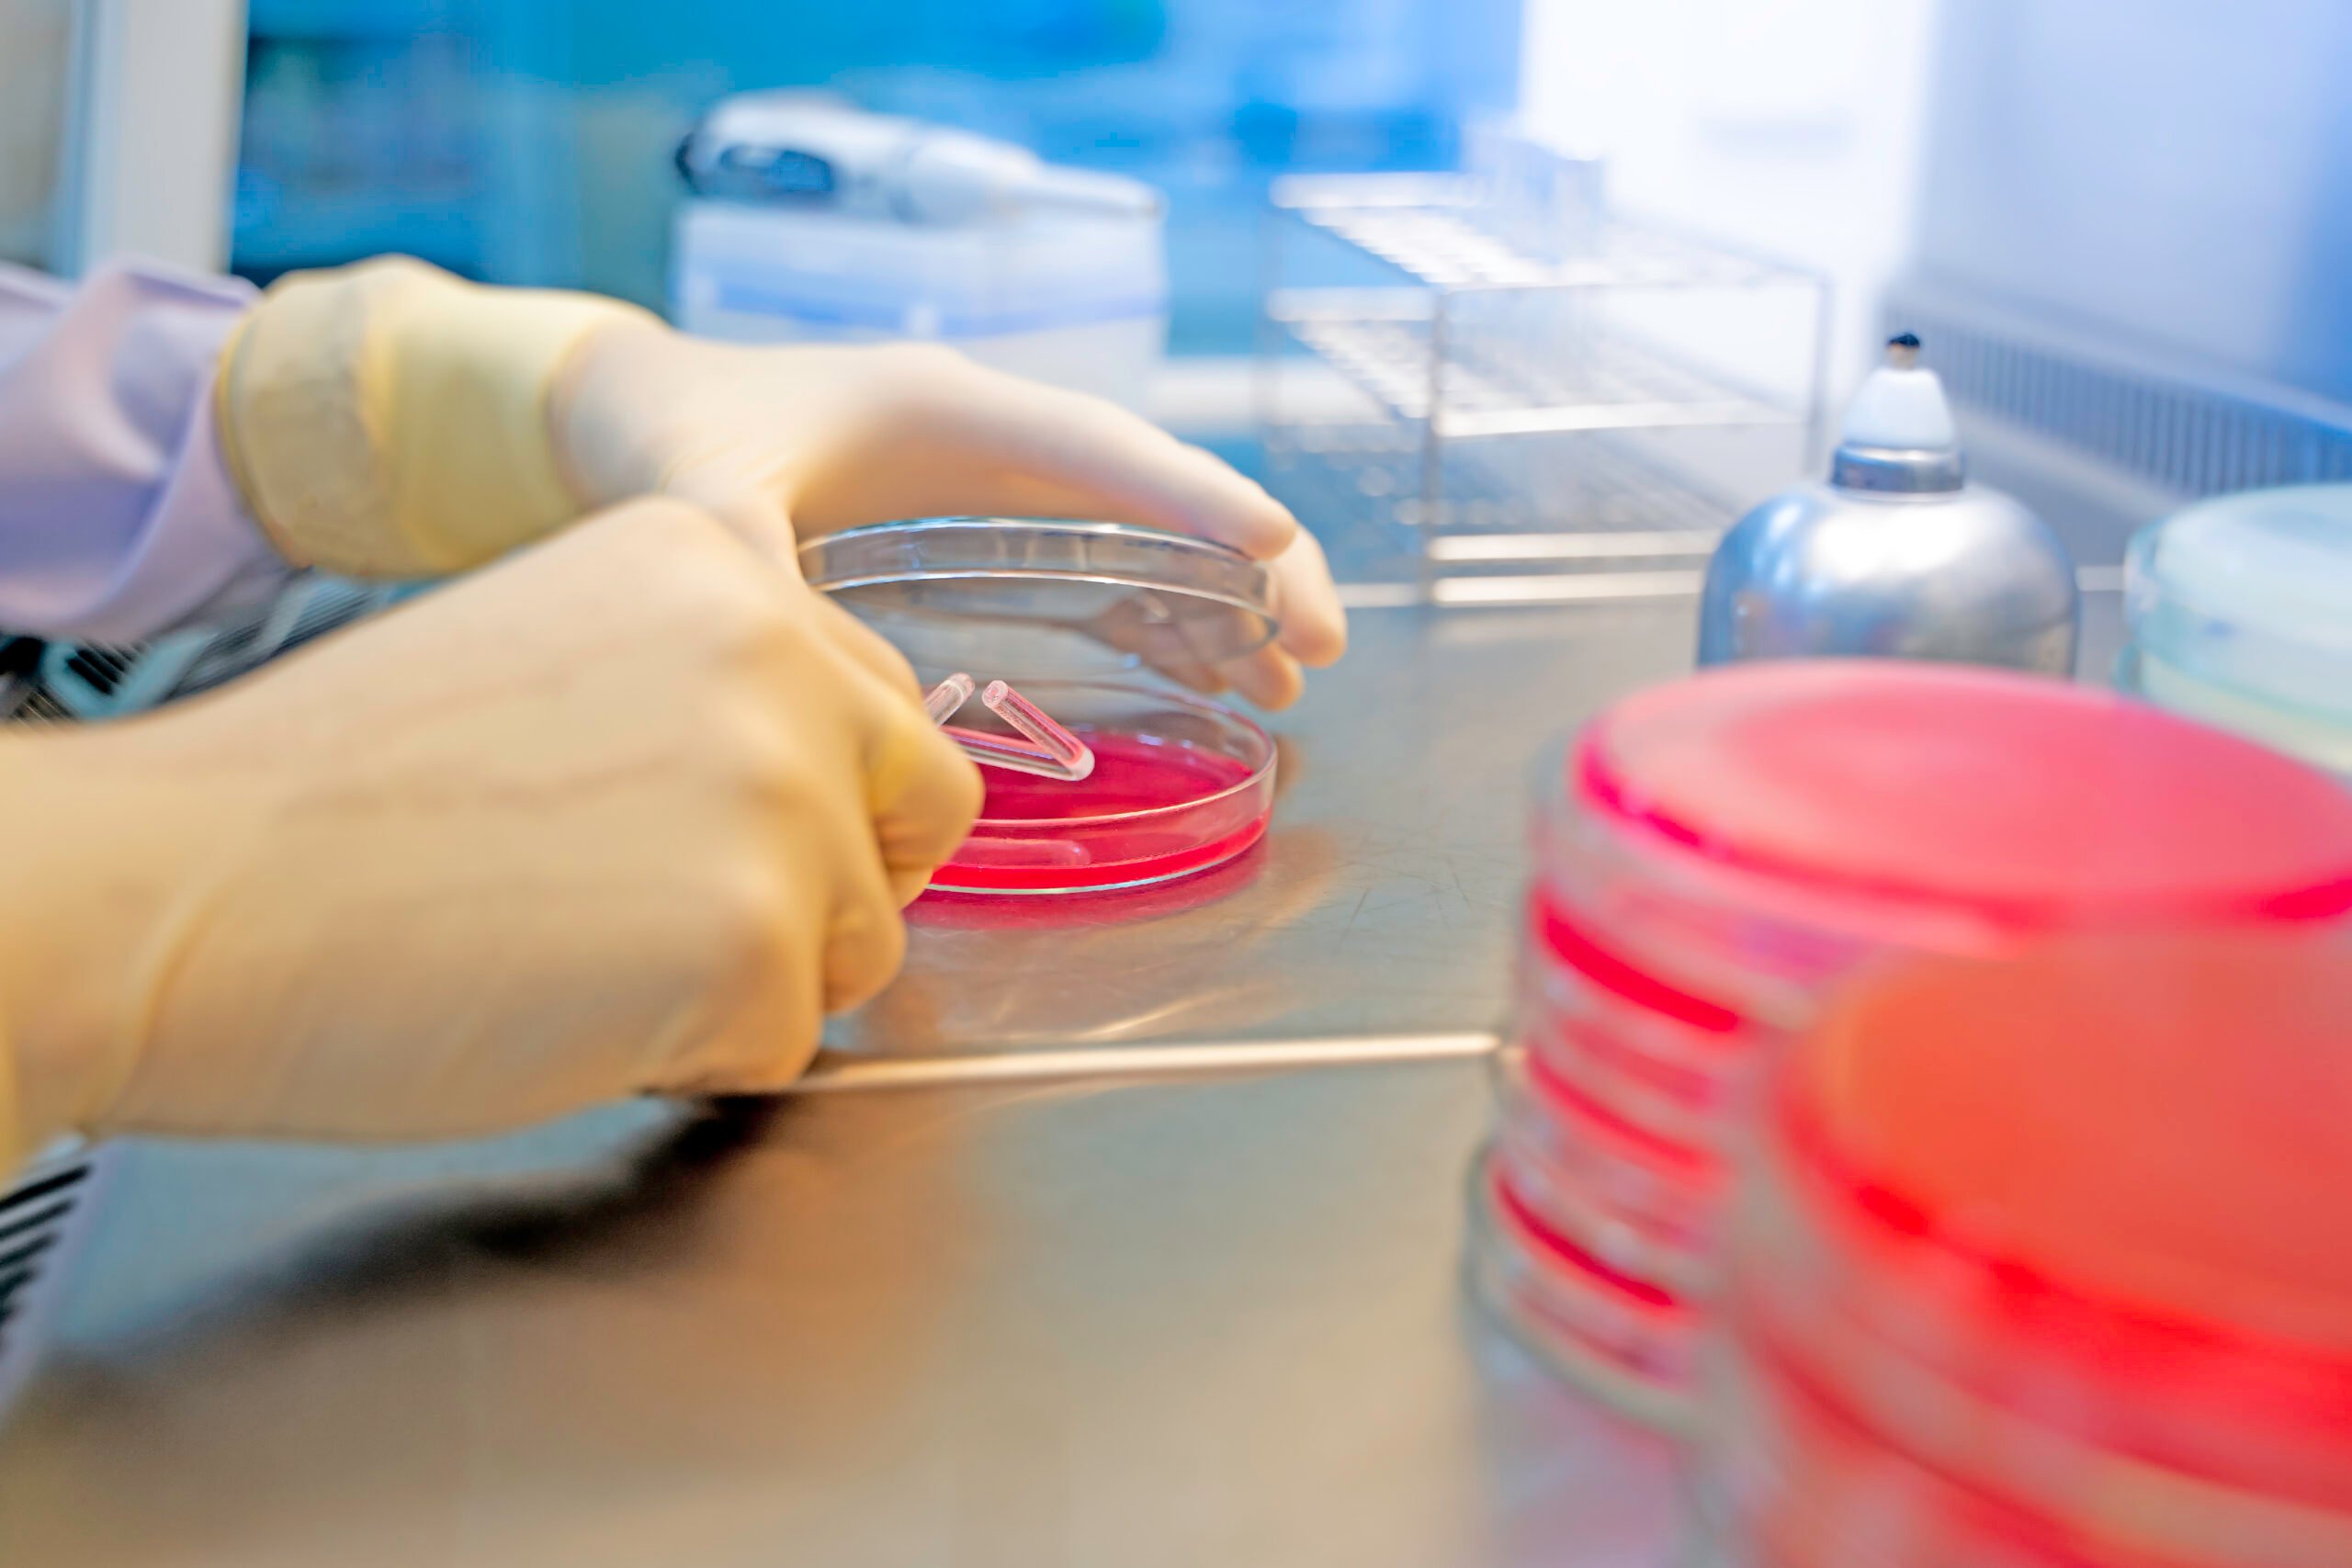

Trei tipuri diferite de alimente au fost retrase de la vânzare din mai multe magazine, după ce analizele efectuate pe probele prelevate din ele au relevat probleme de siguranță. Astfel, a fost emisă o alertă alimentară.
Pe lista alimentelor cu probleme au fost incluse semințele de mac, mierea de tei dar și tradiționala fasole cu cârnați, vândută în caserole. Toate aceste produse prezentau probleme de siguranță.
În cazul semințelor de mac, de pildă, analizele au indicat cantități mari de opiu. Aceste loturi au fost furnizate de mai mulți producători, fiind comercializate dintr-o listă lungă de supermarketuri. Analizele au arătat că s-a depășit limita admisă de morfină și codeină.
Mai mult, testele care au vizat mierea de tei au evidențiat prezența unui antibiotic interzis în Uniunea Europeană.
Analizele de laborator au fost realizate de către Autoritatea Națională Sanitară Veterinară și pentru Siguranța Alimentelor.